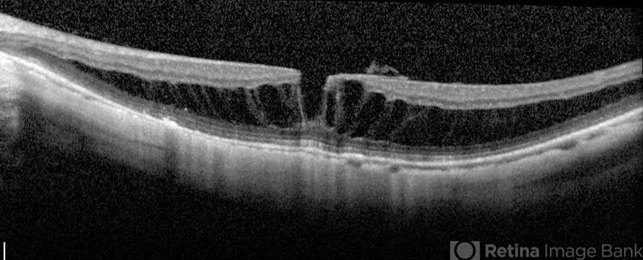

-
 By John T. Thompson, MD
By John T. Thompson, MD
Retina Specialists - Uploaded on May 26, 2014.
- Last modified by Caroline Bozell on May 27, 2014.
- Rating
- Appears in
- Miscellaneous
- Condition/keywords
- myopic macular schisis, lamellar macular hole
- Description
- Spectral domain OCT of patient with high myopia and myopic macular schisis resulting in lamellar macular hole.

Initializing download.
Initializing download.









